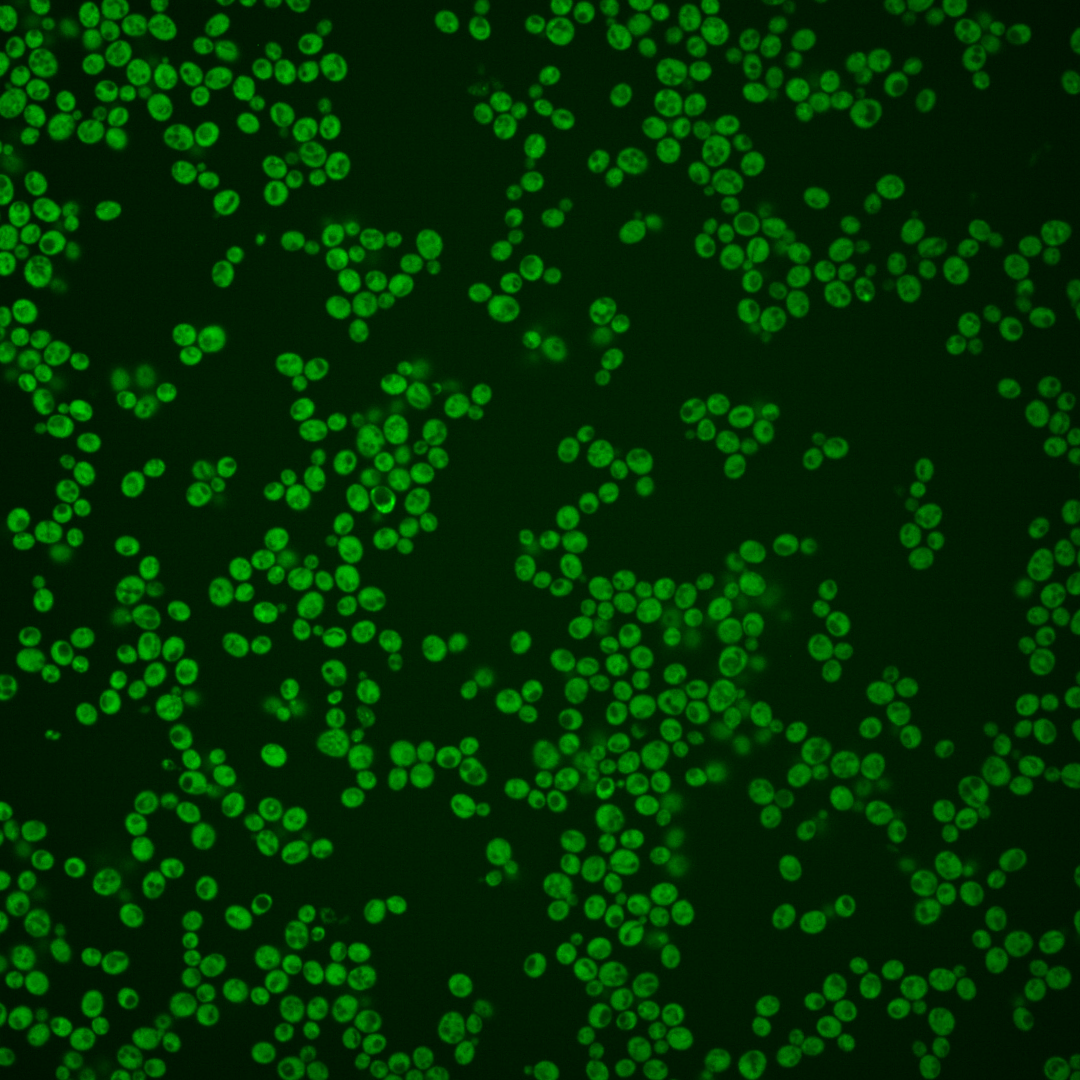
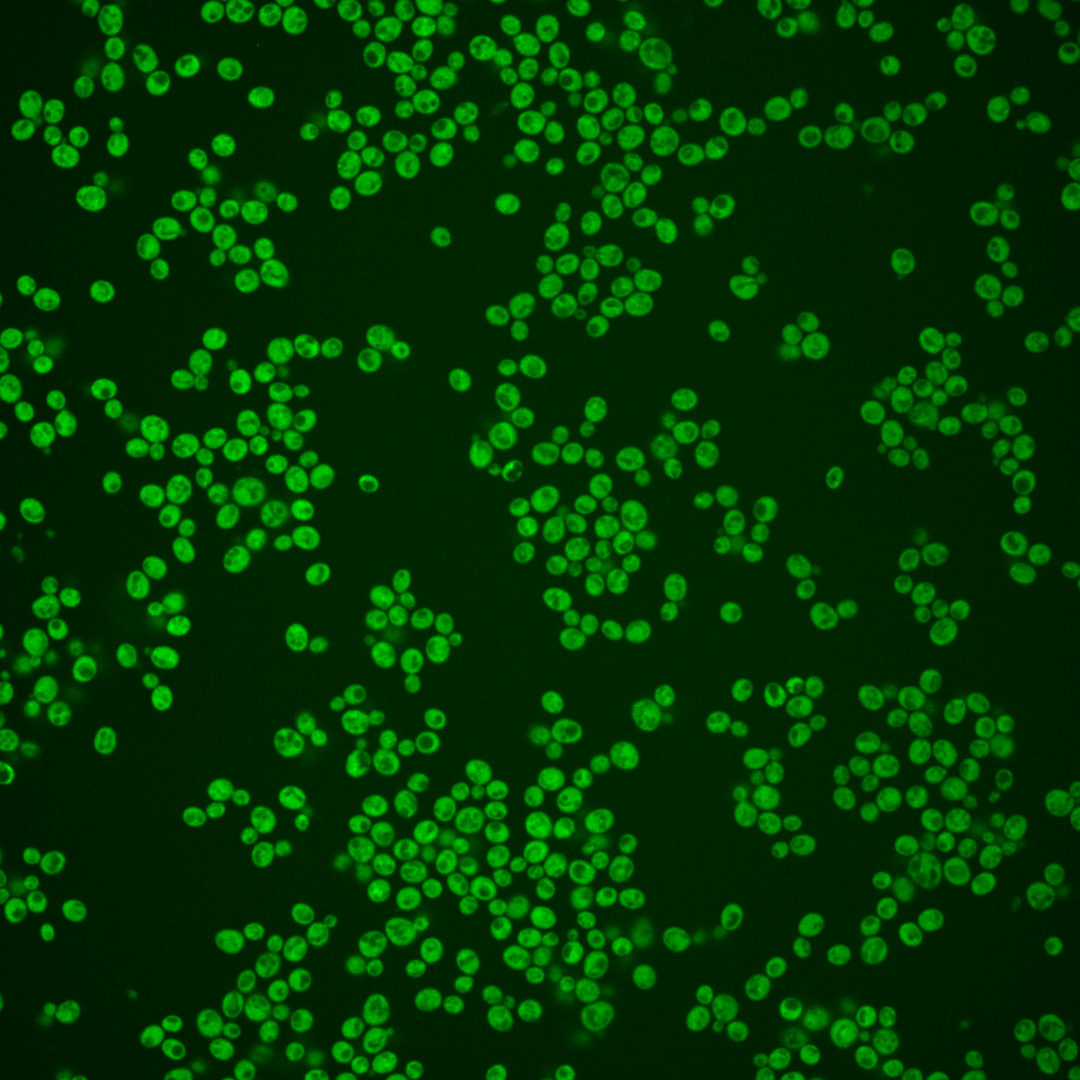
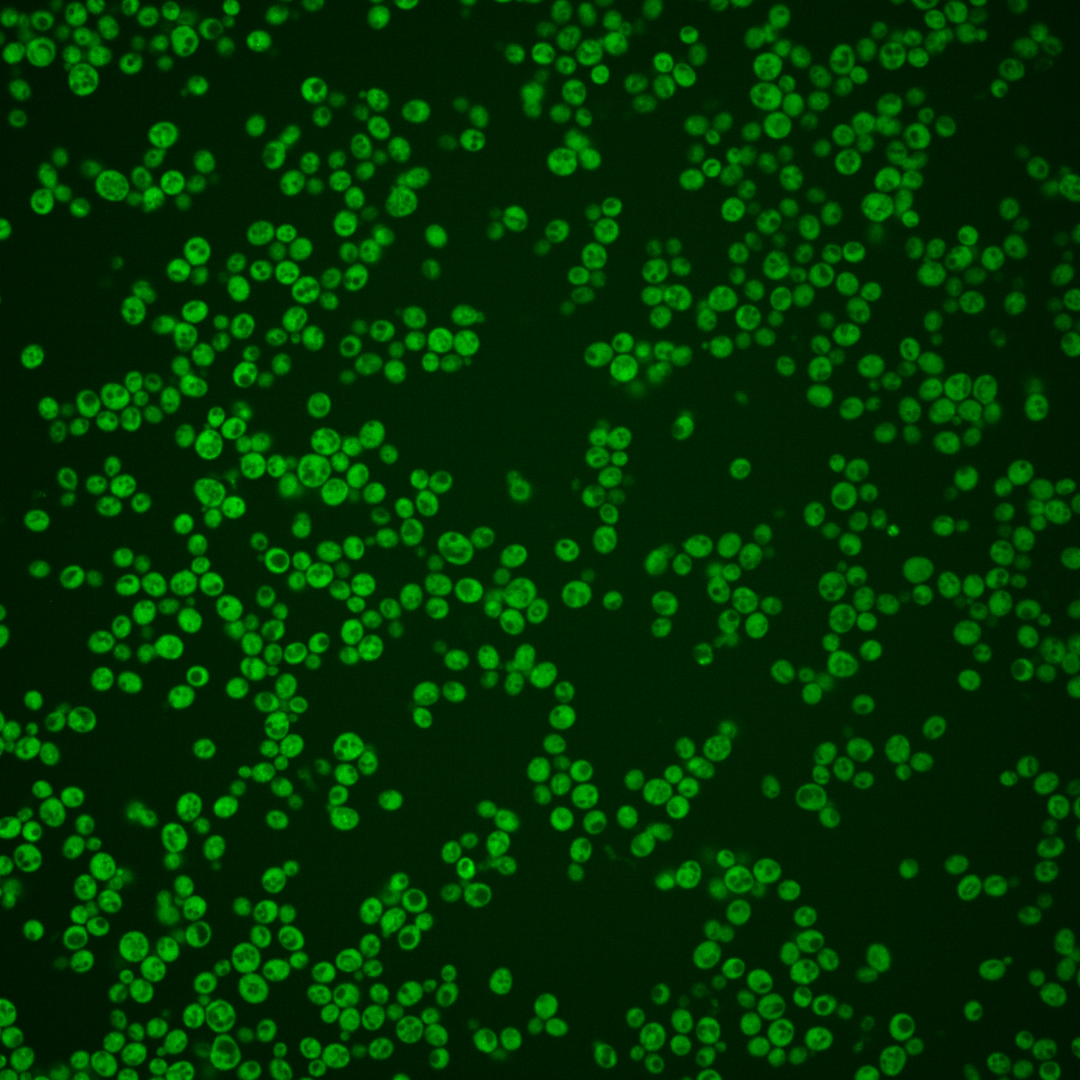
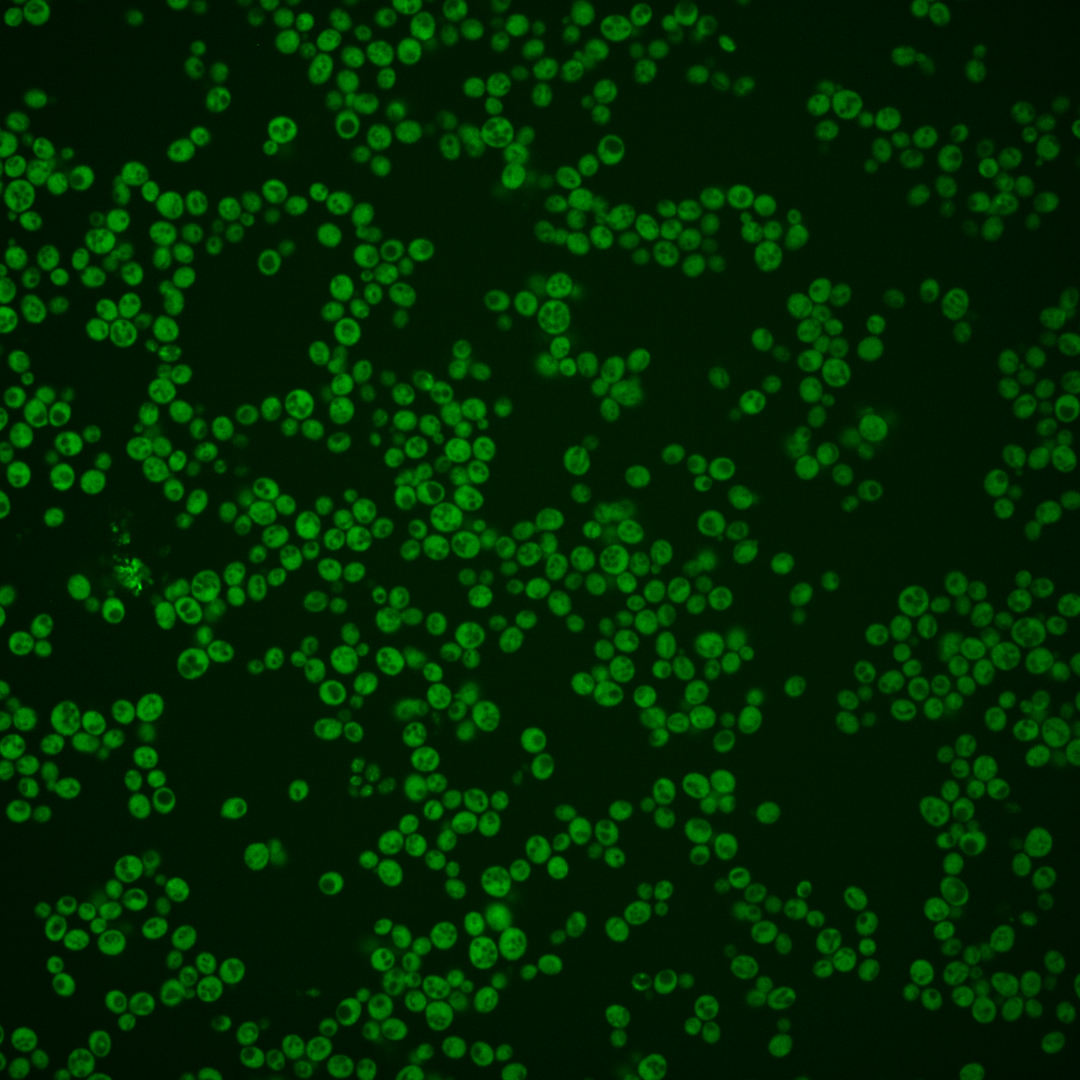
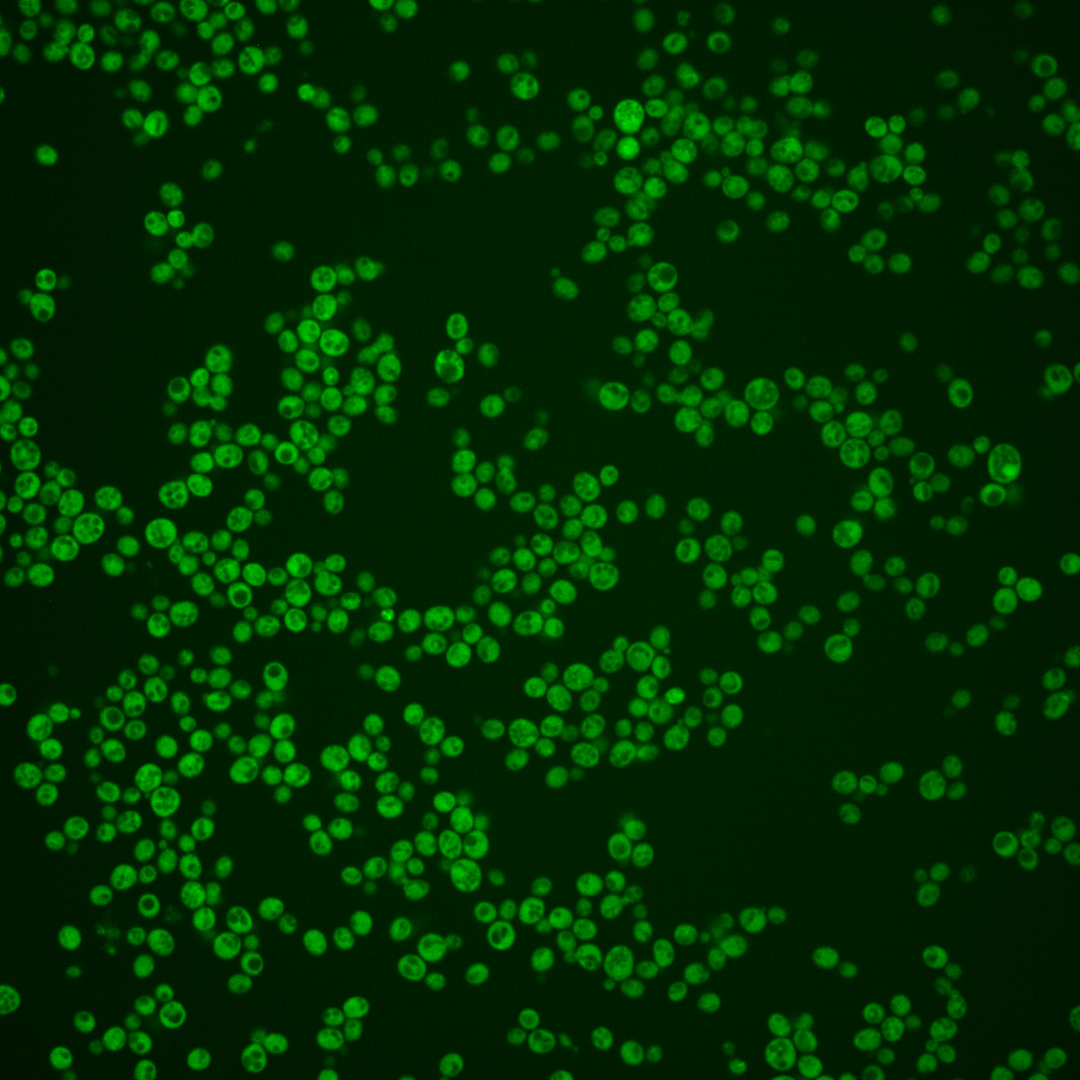
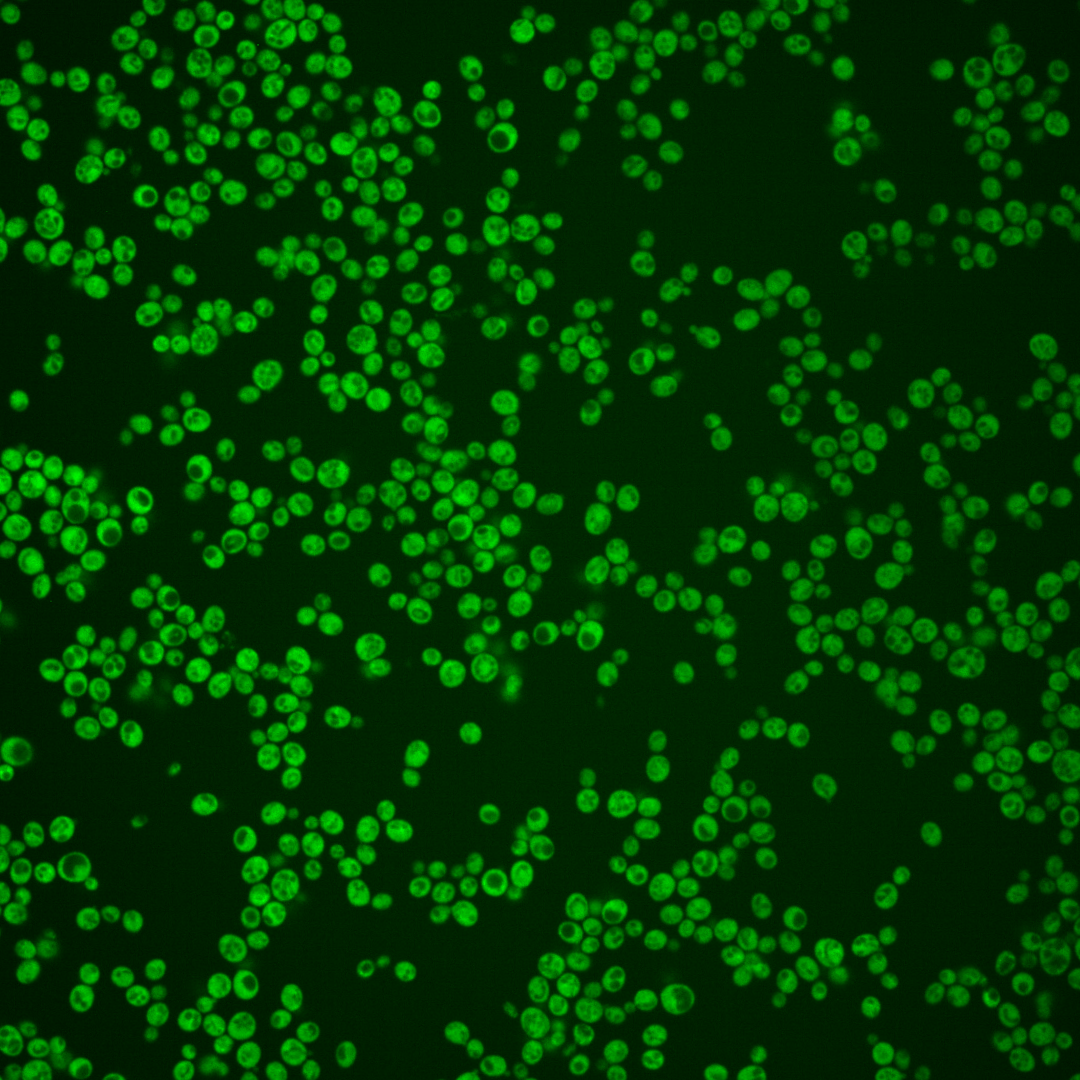

| Standard name | |
|---|---|
| Human Ortholog | |
| Description | RNA-binding protein that may be involved in translational regulation; binds specific categories of mRNAs, including those that contain upstream open reading frames (uORFs) and internal ribosome entry sites (IRES); interacts genetically with chromatin remodelers and splicing factors, linking chromatin state, splicing and as a result mRNA maturation |
Micrographs




















































































Sub-cellular Localization
Yeast GFP Assignment
Protein Abundance
Localization Change
External localization resources
| ensLOC | DeepLoc | |||||||||||||||||||||||
|---|---|---|---|---|---|---|---|---|---|---|---|---|---|---|---|---|---|---|---|---|---|---|---|---|
| Localization | WT1 | WT2 | WT3 | RAP60 | RAP140 | RAP220 | RAP300 | RAP380 | RAP460 | RAP540 | RAP620 | RAP700 | HU80 | HU120 | HU160 | rpd3Δ_1 | rpd3Δ_2 | rpd3Δ_3 | WT1 | WT2 | WT3 | AF100 | AF140 | AF180 |
| Cortical Patches | 0 | 1 | 1 | 0 | 4 | 1 | 7 | 6 | 8 | 12 | 14 | 9 | 0 | 0 | 0 | 0 | 2 | 0 | 0 | 1 | 2 | 0 | 0 | 0 |
| Bud | 0 | 0 | 1 | 0 | 1 | 1 | 3 | 8 | 4 | 2 | 6 | 3 | 2 | 2 | 0 | 1 | 0 | 0 | 0 | 2 | 0 | 0 | 0 | 0 |
| Bud Neck | 0 | 0 | 0 | 0 | 0 | 0 | 0 | 0 | 0 | 0 | 0 | 0 | 0 | 0 | 0 | 0 | 0 | 0 | 0 | 1 | 0 | 0 | 1 | 1 |
| Bud Site | 0 | 0 | 0 | 0 | 0 | 0 | 0 | 0 | 0 | 0 | 0 | 0 | 0 | 0 | 0 | 0 | 0 | 0 | – | – | – | – | – | – |
| Cell Periphery | 2 | 18 | 15 | 7 | 24 | 14 | 18 | 32 | 32 | 46 | 40 | 51 | 18 | 17 | 8 | 17 | 27 | 18 | 0 | 0 | 2 | 0 | 0 | 1 |
| Cytoplasm | 120 | 742 | 420 | 251 | 441 | 415 | 495 | 551 | 446 | 506 | 420 | 432 | 235 | 337 | 264 | 197 | 177 | 217 | 131 | 697 | 382 | 167 | 328 | 259 |
| Endoplasmic Reticulum | 1 | 25 | 23 | 8 | 29 | 32 | 113 | 129 | 69 | 90 | 54 | 69 | 4 | 6 | 6 | 5 | 7 | 7 | 3 | 27 | 52 | 14 | 20 | 11 |
| Endosome | 0 | 1 | 1 | 0 | 1 | 0 | 1 | 1 | 1 | 1 | 0 | 1 | 1 | 0 | 1 | 0 | 2 | 1 | 2 | 4 | 0 | 0 | 4 | 0 |
| Golgi | 0 | 2 | 1 | 1 | 0 | 0 | 2 | 2 | 0 | 1 | 1 | 2 | 1 | 0 | 0 | 0 | 1 | 0 | 0 | 2 | 1 | 0 | 3 | 0 |
| Mitochondria | 0 | 0 | 0 | 4 | 14 | 96 | 94 | 98 | 136 | 139 | 158 | 121 | 0 | 0 | 0 | 1 | 1 | 1 | 0 | 2 | 2 | 1 | 3 | 2 |
| Nucleus | 0 | 2 | 1 | 1 | 2 | 1 | 5 | 2 | 2 | 3 | 4 | 0 | 0 | 0 | 1 | 4 | 1 | 1 | 0 | 1 | 0 | 0 | 0 | 0 |
| Nuclear Periphery | 0 | 0 | 0 | 0 | 0 | 6 | 8 | 3 | 0 | 3 | 2 | 7 | 0 | 0 | 0 | 0 | 0 | 0 | 0 | 1 | 0 | 0 | 2 | 0 |
| Nucleolus | 0 | 0 | 0 | 0 | 1 | 1 | 0 | 0 | 0 | 0 | 0 | 1 | 0 | 0 | 0 | 0 | 0 | 1 | 0 | 0 | 0 | 0 | 0 | 0 |
| Peroxisomes | 0 | 0 | 0 | 0 | 0 | 0 | 0 | 0 | 0 | 0 | 0 | 0 | 0 | 0 | 0 | 0 | 0 | 0 | 0 | 0 | 0 | 0 | 0 | 0 |
| SpindlePole | 0 | 0 | 0 | 0 | 0 | 0 | 0 | 0 | 0 | 0 | 0 | 0 | 0 | 0 | 0 | 0 | 0 | 0 | 0 | 0 | 0 | 0 | 0 | 0 |
| Vac/Vac Membrane | 0 | 1 | 5 | 5 | 26 | 22 | 46 | 63 | 69 | 54 | 26 | 66 | 2 | 0 | 4 | 4 | 7 | 6 | 1 | 6 | 1 | 4 | 6 | 4 |
| Unique Cell Count | 120 | 764 | 446 | 264 | 511 | 520 | 719 | 808 | 673 | 751 | 622 | 664 | 243 | 342 | 276 | 208 | 194 | 228 | 141 | 755 | 451 | 192 | 374 | 287 |
| Labelled Cell Count | 123 | 792 | 468 | 277 | 543 | 589 | 792 | 895 | 767 | 857 | 725 | 762 | 263 | 362 | 284 | 229 | 225 | 252 | 141 | 755 | 451 | 192 | 374 | 287 |
Yeast GFP Assignment
Protein Abundance
| Screen | WT1 | WT2 | WT3 | RAP60 | RAP140 | RAP220 | RAP300 | RAP380 | RAP460 | RAP540 | RAP620 | RAP700 | HU80 | HU120 | HU160 | rpd3Δ_1 | rpd3Δ_2 | rpd3Δ_3 | AF100 | AF140 | AF180 |
|---|---|---|---|---|---|---|---|---|---|---|---|---|---|---|---|---|---|---|---|---|---|
| Mean Cell GFP Intensity (1e-4) | 13.3 | 13.8 | 12.5 | 11.9 | 11.0 | 9.9 | 9.9 | 10.4 | 10.0 | 10.0 | 9.8 | 10.2 | 13.5 | 13.0 | 13.0 | 11.8 | 11.9 | 12.0 | 11.1 | 11.4 | 11.4 |
| Std Deviation (1e-4) | 1.5 | 1.9 | 2.0 | 2.0 | 1.8 | 1.9 | 1.9 | 1.9 | 2.2 | 2.1 | 2.1 | 2.1 | 1.5 | 1.3 | 1.6 | 2.2 | 2.4 | 2.1 | 1.2 | 1.3 | 1.3 |
| Intensity Change (Log2) | – | – | – | -0.07 | -0.17 | -0.34 | -0.33 | -0.26 | -0.32 | -0.32 | -0.35 | -0.3 | 0.12 | 0.06 | 0.07 | -0.08 | -0.07 | -0.06 | -0.16 | -0.13 | -0.12 |
Localization Change
| Localization | RAP60 | RAP140 | RAP220 | RAP300 | RAP380 | RAP460 | RAP540 | RAP620 | RAP700 | HU80 | HU120 | HU160 | rpd3Δ_1 | rpd3Δ_2 | rpd3Δ_3 |
|---|---|---|---|---|---|---|---|---|---|---|---|---|---|---|---|
| Cortical Patches | 0 | 0 | 0 | 0 | 0 | 0 | 0 | 2.8 | 0 | 0 | 0 | 0 | 0 | 0 | 0 |
| Bud | 0 | 0 | 0 | 0 | 0 | 0 | 0 | 0 | 0 | 0 | 0 | 0 | 0 | 0 | 0 |
| Bud Neck | 0 | 0 | 0 | 0 | 0 | 0 | 0 | 0 | 0 | 0 | 0 | 0 | 0 | 0 | 0 |
| Bud Site | 0 | 0 | 0 | 0 | 0 | 0 | 0 | 0 | 0 | 0 | 0 | 0 | 0 | 0 | 0 |
| Cell Periphery | -0.5 | 1.0 | -0.6 | -0.9 | 0.5 | 1.1 | 2.1 | 2.2 | 3.0 | 2.4 | 1.1 | -0.3 | 2.7 | 5.0 | 2.6 |
| Cytoplasm | 0.5 | -4.0 | -6.5 | -10.2 | -10.5 | -10.9 | -10.7 | -10.5 | -11.3 | 1.5 | 3.1 | 0.9 | 0.3 | -1.4 | 0.5 |
| Endoplasmic Reticulum | -1.3 | 0.4 | 0.7 | 5.5 | 5.6 | 3.0 | 3.9 | 2.2 | 3.1 | -2.3 | -2.5 | -2.0 | -1.6 | -0.9 | -1.2 |
| Endosome | 0 | 0 | 0 | 0 | 0 | 0 | 0 | 0 | 0 | 0 | 0 | 0 | 0 | 0 | 0 |
| Golgi | 0 | 0 | 0 | 0 | 0 | 0 | 0 | 0 | 0 | 0 | 0 | 0 | 0 | 0 | 0 |
| Mitochondria | 0 | 3.5 | 9.6 | 8.0 | 7.7 | 10.1 | 9.7 | 11.5 | 9.6 | 0 | 0 | 0 | 0 | 0 | 0 |
| Nucleus | 0 | 0 | 0 | 0 | 0 | 0 | 0 | 0 | 0 | 0 | 0 | 0 | 0 | 0 | 0 |
| Nuclear Periphery | 0 | 0 | 0 | 0 | 0 | 0 | 0 | 0 | 0 | 0 | 0 | 0 | 0 | 0 | 0 |
| Nucleolus | 0 | 0 | 0 | 0 | 0 | 0 | 0 | 0 | 0 | 0 | 0 | 0 | 0 | 0 | 0 |
| Peroxisomes | 0 | 0 | 0 | 0 | 0 | 0 | 0 | 0 | 0 | 0 | 0 | 0 | 0 | 0 | 0 |
| SpindlePole | 0 | 0 | 0 | 0 | 0 | 0 | 0 | 0 | 0 | 0 | 0 | 0 | 0 | 0 | 0 |
| Vacuole | 0 | 3.5 | 2.9 | 4.3 | 5.0 | 6.0 | 4.7 | 2.9 | 5.9 | 0 | 0 | 0 | 0 | 0 | 0 |
External localization resources
Images






























Protein Concentration and Protein Localization Data
| R1 | R2 | R3 | ||||||||||||||||
|---|---|---|---|---|---|---|---|---|---|---|---|---|---|---|---|---|---|---|
| G1 Pre-START | G1 Post-START | S/G2 | Metaphase | Anaphase | Telophase | G1 Pre-START | G1 Post-START | S/G2 | Metaphase | Anaphase | Telophase | G1 Pre-START | G1 Post-START | S/G2 | Metaphase | Anaphase | Telophase | |
| Concentration | 7.2246 | 10.0472 | 8.507 | 8.7002 | 7.0039 | 9.1108 | 10.1587 | 12.6368 | 11.5673 | 10.8542 | 10.4775 | 11.7355 | 8.3619 | 9.4822 | 8.4417 | 8.7841 | 9.3831 | 9.7182 |
| Actin | 0.0261 | 0.0003 | 0.0102 | 0.0122 | 0.0605 | 0.0108 | 0.0187 | 0.0083 | 0.0119 | 0.0207 | 0.0152 | 0.0092 | 0.0098 | 0.0006 | 0.036 | 0.0003 | 0.001 | 0.0004 |
| Bud | 0.0005 | 0.0001 | 0.0002 | 0.0009 | 0.0021 | 0.0003 | 0.0029 | 0.0104 | 0.0041 | 0.0331 | 0.0034 | 0.003 | 0.0005 | 0.0001 | 0.0014 | 0.0001 | 0.0002 | 0.0001 |
| Bud Neck | 0.0019 | 0.0001 | 0.0004 | 0.0007 | 0.0017 | 0.0011 | 0.0009 | 0.0003 | 0.0008 | 0.0014 | 0.0012 | 0.0021 | 0.0008 | 0.0003 | 0.0004 | 0.0002 | 0.0003 | 0.0005 |
| Bud Periphery | 0.0003 | 0 | 0.0002 | 0.0011 | 0.0019 | 0.0003 | 0.0024 | 0.004 | 0.0025 | 0.0163 | 0.0016 | 0.0022 | 0.0009 | 0.0001 | 0.0012 | 0 | 0 | 0 |
| Bud Site | 0.0025 | 0.0002 | 0.0005 | 0.003 | 0.0029 | 0.0004 | 0.0032 | 0.0128 | 0.01 | 0.0115 | 0.0011 | 0.0017 | 0.006 | 0.0008 | 0.0051 | 0 | 0.0001 | 0 |
| Cell Periphery | 0.0001 | 0 | 0.0001 | 0.0001 | 0.0003 | 0.0001 | 0.0005 | 0.0005 | 0.0004 | 0.001 | 0.0002 | 0.0002 | 0.0003 | 0.0001 | 0.0002 | 0 | 0 | 0 |
| Cytoplasm | 0.7916 | 0.969 | 0.8729 | 0.8273 | 0.702 | 0.911 | 0.7759 | 0.9293 | 0.8697 | 0.7731 | 0.8744 | 0.9291 | 0.8402 | 0.9682 | 0.8162 | 0.8801 | 0.9779 | 0.9344 |
| Cytoplasmic Foci | 0.0416 | 0.0025 | 0.0101 | 0.0066 | 0.0209 | 0.0082 | 0.0235 | 0.0042 | 0.0117 | 0.021 | 0.017 | 0.0119 | 0.0276 | 0.0034 | 0.0199 | 0.0055 | 0.0028 | 0.0058 |
| Eisosomes | 0.0002 | 0 | 0.0001 | 0.0001 | 0.0017 | 0.0001 | 0.0001 | 0 | 0.0001 | 0.0004 | 0.0001 | 0 | 0.0001 | 0 | 0.0002 | 0 | 0 | 0 |
| Endoplasmic Reticulum | 0.0402 | 0.0209 | 0.0417 | 0.1007 | 0.0198 | 0.023 | 0.0463 | 0.0112 | 0.0378 | 0.0511 | 0.0142 | 0.0144 | 0.0385 | 0.0065 | 0.0201 | 0.0716 | 0.0098 | 0.0287 |
| Endosome | 0.0303 | 0.0029 | 0.032 | 0.008 | 0.0738 | 0.0166 | 0.0535 | 0.0026 | 0.014 | 0.0148 | 0.0248 | 0.0083 | 0.0159 | 0.003 | 0.0309 | 0.0245 | 0.0023 | 0.0191 |
| Golgi | 0.0072 | 0.0002 | 0.0075 | 0.004 | 0.0145 | 0.0043 | 0.014 | 0.0005 | 0.0061 | 0.0022 | 0.0112 | 0.0007 | 0.003 | 0.0016 | 0.0207 | 0.0007 | 0.0003 | 0.0007 |
| Lipid Particles | 0.0078 | 0 | 0.0038 | 0.0029 | 0.0382 | 0.0049 | 0.0045 | 0.0001 | 0.0035 | 0.0051 | 0.0012 | 0.0003 | 0.0068 | 0.006 | 0.0059 | 0.0004 | 0 | 0 |
| Mitochondria | 0.0021 | 0.0001 | 0.0035 | 0.0139 | 0.005 | 0.0016 | 0.0144 | 0.0003 | 0.005 | 0.0135 | 0.0038 | 0.0008 | 0.0037 | 0.0016 | 0.0101 | 0.0003 | 0.0001 | 0.0011 |
| None | 0.0044 | 0.0007 | 0.0016 | 0.0009 | 0.0113 | 0.0014 | 0.0088 | 0.0026 | 0.0069 | 0.0154 | 0.0026 | 0.0032 | 0.0037 | 0.0006 | 0.0025 | 0.0007 | 0.001 | 0.0007 |
| Nuclear Periphery | 0.0145 | 0.0016 | 0.0073 | 0.0047 | 0.0115 | 0.0033 | 0.011 | 0.001 | 0.0033 | 0.0049 | 0.0015 | 0.005 | 0.0039 | 0.0025 | 0.0037 | 0.0103 | 0.0017 | 0.0029 |
| Nucleolus | 0.0003 | 0 | 0.0001 | 0.0001 | 0.0012 | 0.0001 | 0.0005 | 0.0001 | 0.0003 | 0.001 | 0.0181 | 0.0003 | 0.0002 | 0.0003 | 0.0003 | 0 | 0 | 0 |
| Nucleus | 0.0037 | 0.001 | 0.0018 | 0.0024 | 0.0034 | 0.0019 | 0.0046 | 0.0093 | 0.003 | 0.004 | 0.0036 | 0.003 | 0.0016 | 0.0012 | 0.0028 | 0.0027 | 0.0018 | 0.0028 |
| Peroxisomes | 0.0148 | 0 | 0.0021 | 0.0083 | 0.0127 | 0.0047 | 0.0022 | 0.0001 | 0.0016 | 0.0015 | 0.0015 | 0.0003 | 0.0152 | 0.0018 | 0.0093 | 0 | 0 | 0 |
| Punctate Nuclear | 0.0037 | 0.0001 | 0.0006 | 0.0003 | 0.0076 | 0.0032 | 0.004 | 0.0007 | 0.0043 | 0.0028 | 0.0008 | 0.0022 | 0.0116 | 0.0002 | 0.0112 | 0.0003 | 0.0002 | 0.0001 |
| Vacuole | 0.0048 | 0.0004 | 0.0027 | 0.0014 | 0.0047 | 0.002 | 0.006 | 0.0014 | 0.0022 | 0.0039 | 0.0018 | 0.0016 | 0.0075 | 0.0008 | 0.0012 | 0.0017 | 0.0004 | 0.0018 |
| Vacuole Periphery | 0.0014 | 0.0001 | 0.0009 | 0.0005 | 0.0023 | 0.0007 | 0.002 | 0.0002 | 0.0007 | 0.0013 | 0.0009 | 0.0005 | 0.0024 | 0.0002 | 0.0008 | 0.0007 | 0.0001 | 0.0008 |
Sequencing Data
| R1 | R2 | |||||||||
|---|---|---|---|---|---|---|---|---|---|---|
| G1 Post-START | S/G2 | Metaphase | Anaphase | Telophase | G1 Post-START | S/G2 | Metaphase | Anaphase | Telophase | |
| Gene Expression | 47.1002 | 33.791 | 44.5767 | 45.6305 | 36.5627 | 43.7759 | 37.9623 | 46.6686 | 35.7289 | 46.7322 |
| Translational Efficiency | 0.6803 | 0.9455 | 0.6521 | 0.6847 | 0.7869 | 0.6746 | 0.7747 | 0.6077 | 0.7736 | 0.6356 |
Hit Data
| Dataset | Hit |
|---|---|
| Protein Concentration | ✘ |
| Protein Localization | ✘ |
| Gene Expression | ✘ |
| Translational Efficiency | ✘ |
Endocytosis
| Temp | Actin Patch (Sac6-tdTomato) | Cortical Patch (Sla1-GFP) | Late Endosome (Snf7-GFP) | Vacuole (Vph1-GFP) |
|---|---|---|---|---|
| 37℃ | ||||
| RT |
Cell Cycle Omics
CYCLoPs (Mrn1-GFP)
| Gene / Allele | Actin Patch (Sac6-tdTomato) | Cortical Patch (Sla1-GFP) | Late Endosome (Snf7-GFP) | Vacuole (Sac6-tdTomato) |
|---|
| Gene | Images |
|---|
| Gene | Images |
|---|
Images are not yet available
Images are not yet available